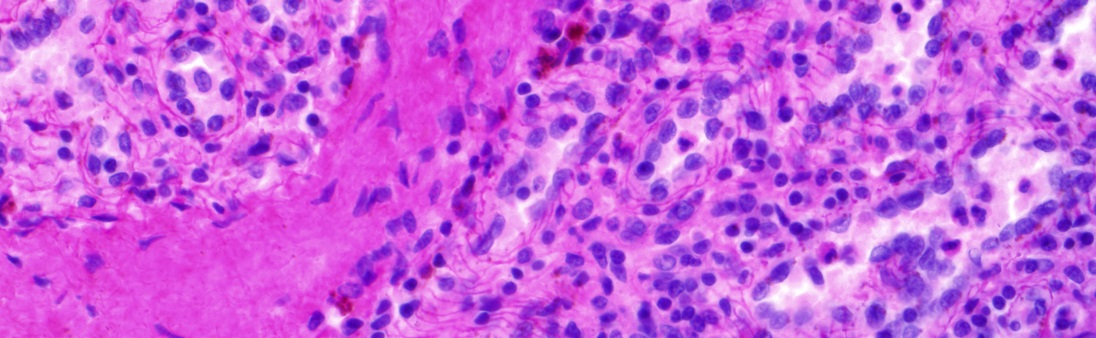
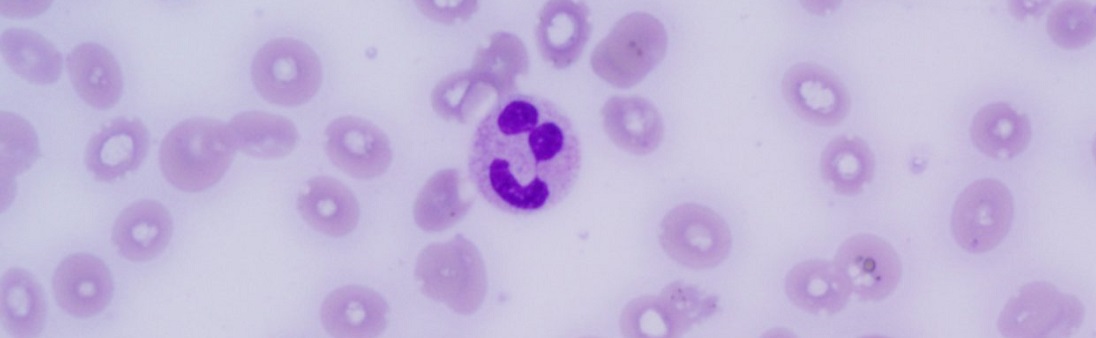

Herzlich willkommen auf den Seiten der Pathologie Koblenz
Zum Wohle der Patienten unterstützen wir seit über 50 Jahren unsere einsendenden Kollegen aus dem ambulanten und stationären Bereich bei Diagnostik und Therapie mit Methoden modernster Untersuchungstechnik.
Wir betreuen jährlich über 80.000 Eingänge aus allen Bereichen der operativen und konservativen Medizin. Das medizinische Untersuchungsgut umfasst große Operationspräparate, Biopsien sowie Aspirations- und Abstrichzytologien.
Unter der Maxime einer klinischen Pathologie erfolgen die Untersuchungen in enger Zusammenarbeit mit den ärztlichen Kollegen und sind essentieller Bestandteil der klinischen Diagnostik und Therapieplanung.
Bei zahlreichen interdisziplinären Konferenzen und Tumorboards wird die klinische Pathologie durch unsere Anwesenheit gelebt.
Unsere Kooperationspartner
- Zertifiziertes Zentrum für Hämatologische Neoplasien Koblenz
- Zertifiziertes Darmkrebszentrum Kemperhof Koblenz
- Zertifiziertes Pankreaskrebszentrum Kemperhof Koblenz
- Zertifiziertes Viszeralonkologisches Zentrum Kemperhof Koblenz
- Prostatakarzinomzentrum
- Darmkrebszentrum Marienhaus Klinikum Ahrweiler
- Mammographie-Screening Programm Mittelrhein
- Zertifiziertes Brustzentrum Kemperhof Koblenz-St. Elisabeth Mayen
- Brustzentrum Bad Neuenahr-Ahrweiler
- Interdisziplinäres Lungenkrebszentrum Koblenz
- Brust-, HNO- und Lungenzentrum Kath. Klinikum Marienhof/ Montabaur

Die Fachärzte für Pathologie sind Mitglieder in nationalen und internationalen Fachgesellschaften:
- Berufsverband Deutscher Pathologen
- Deutsche Gesellschaft für Pathologie DGP
- Deutsche Gesellschaft für Senologie
- Deutsche Gesellschaft für Zytologie
- Deutsche Krebsgesellschaft DKG
- European Association for Hematopathology EAHP
- Gesellschaft Deutschsprachiger Lymphologen GDL
- European Bone Marrow Working Group EBMWG
- European Society of Pathology ESP
- European Neuroendocrine Tumor Society ENETS
- Internationale Akademie für Pathologie
- Internationale Akademie für Zytologie
- Society for Hematopathology
- Krebsgesellschaft Rheinland-Pfalz
- European Association for Cancer Research EACR
- Arbeitsgemeinschaft Dermatohistologie
„Aus Erfahrung, Präzision und Liebe zum Detail wird Qualität." (Gellner)

 Schrift vergrößern
Schrift vergrößern Weißpunkt reduzieren
Weißpunkt reduzieren Graustufen aktivieren
Graustufen aktivieren Einstellungen aufheben
Einstellungen aufheben